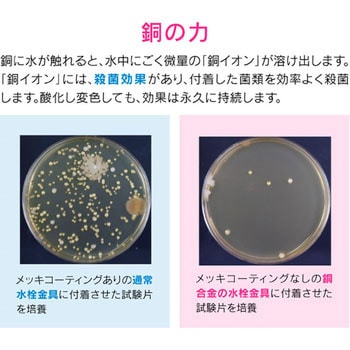

これカモ シンク用 銅製ゴミカゴ 排水口のゴミ受け (殺菌効果 ヌメリ・臭い防止 衛生的)
(1件のレビュー)キッチンのシンク用の浅型ゴミカゴです。
銅イオンの殺菌効果でヌメリやにおいを防ぎます。
取っ手が付いているので、取外しが簡単です。
浅型ゴミカゴなので、こまめなゴミ捨てでいつも清潔です。
※使用を重ねるうちに黒ずんでいき、しだいに薄青みがかった皮膜に変色しますが、銅イオンの殺菌効果は変わりません。
用途キッチン・台所材質銅上径×下径×高さH(mm)78×59×35アズワン品番64-5153-99内容量1個
水廻り部材 の新着商品
カテゴリ



商品レビュー
対象商品 : 31517843
2021-05-23
用途: キッチンの排水溝のゴミ受けに
製造業
ゴミ受けがぬめらないってこういうことなのかと感激しました。
水気がなくなればゴミがカピカピになりすごく掃除がしやすいです。
銅製を買って正解でした。